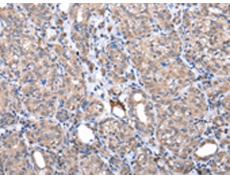
一抗

中文名稱 : 兔抗ZNF217多克隆抗體
|
Background: |
ZNF217, also known as ZABC1, is a zinc finger protein belonging to the Krüppel C2H2-type zinc-finger protein family. It localizes to the nucleus and may play a role in transcriptional repression of a variety of genes through the recruitment of co-repressor complexes containing proteins such as CtBP, HDAC1 and HDAC2. In addition, ZNF217 participates in cell differentiation and appears to function as an oncogene. Expression of ZNF217 is amplified in various tumors and overexpression of the protein can attenuate apoptotic signals and lead to epithelial cell immortalization.Binds to the promoters of target genes and functions as repressor. Promotes cell proliferation and antagonizes cell death. Promotes phosphorylation of AKT1 at 'Ser-473'. |
|
Applications: |
ELISA, IHC |
|
Name of antibody: |
ZNF217 |
|
Immunogen: |
Fusion protein of human ZNF217 |
|
Full name: |
zinc finger protein 217 |
|
Synonyms: |
ZABC1 |
|
SwissProt: |
O75362 |
|
ELISA Recommended dilution: |
2000-5000 |
|
IHC positive control: |
Human prostate cancer |
|
IHC Recommend dilution: |
25-100 |

 購物車
購物車 幫助
幫助
 021-54845833/15800441009
021-54845833/15800441009